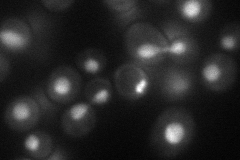
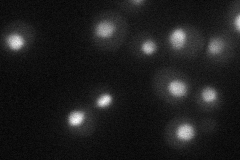
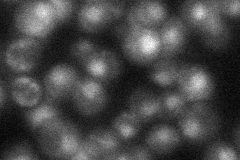
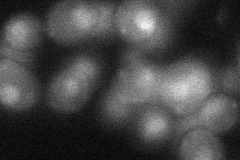
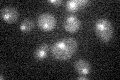

View description
Protein involved in negative regulation of expression of spliceosome components PRP4 and PRP3
Localization:
Intensity:
Fold change:
Significance:
-
C’ GFP library in SD

nucleus22.45 -
N' NOP1pr-GFP in SD
nucleolus51.0895 -
N' TEF2pr-mCherry in SD
nucleus32.8393 -
N' NATIVEpr-GFP in SD
nucleus30.1693 -
N' TEF2pr-VC and Cyto-VN in SD
nucleus38.4977 -
C’ GFP library in SD+DTT

nucleus18.510.82No -
C’ GFP library in SD+H2O2

nucleus22.781.01No -
C’ GFP library in Starvation Media
nucleus18.480.82No -
C’ GFP library on the background of Pup2-DaMP

nucleus -
C’ GFP library on the background of CCT mutant

nucleus29.94151.33312No
